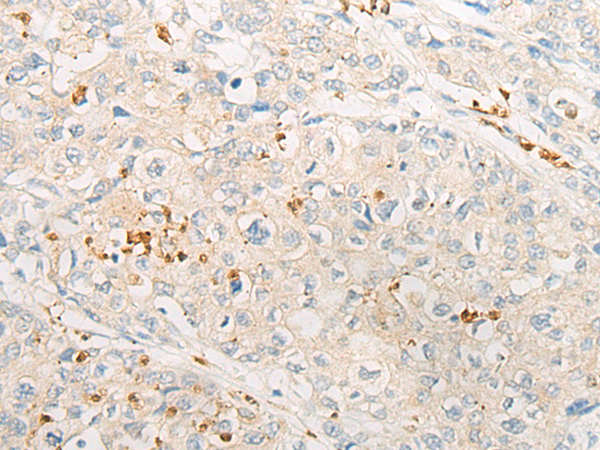
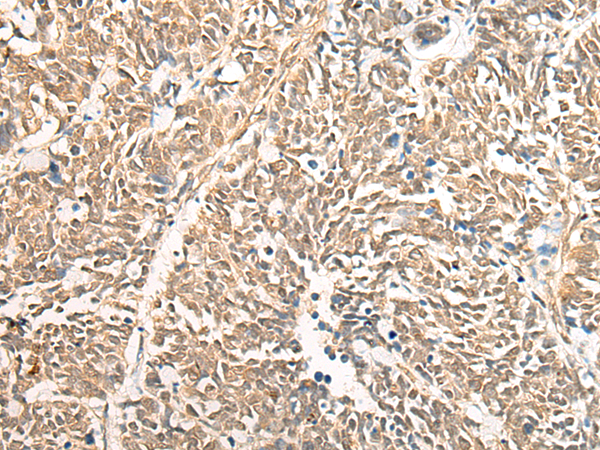

-
分类: 科研抗体货号: P06387别名: DMGDHD; ME2GLYDH应用: WB反应种属: Human
-
分类: 科研抗体货号: P06324别名: GRFR; GHRFR; IGHD1B应用: IHC反应种属: Human
-
分类: 科研抗体货号: P06385别名: SCDO1应用: IHC反应种属: Human
-
分类: 科研抗体货号: P06384别名: DAP4; DLP4; DAP-4; SAPAP4; SAPAP-4应用: WB反应种属: Human, Mouse, Rat
-
分类: 科研抗体货号: P06380别名: RRP44; dis3p; EXOSC11; KIAA1008; 2810028N01Rik应用: IHC反应种属: Human
-
分类: 科研抗体货号: P06379别名:应用: WB,IHC反应种属: Human, Mouse
-
分类: 科研抗体货号: P06377别名: dgkd-2; DGKdelta应用: IHC反应种属: Human
-
分类: 科研抗体货号: P06363别名: CRS5; FND2应用: IHC反应种属: Human, Mouse
-
分类: 科研抗体货号: P06376别名:应用: WB,IHC反应种属: Human, Mouse
-
分类: 科研抗体货号: P06360别名: SPG28; PAPLA1; PA-PLA1应用: IHC反应种属: Human

鄂公网安备42018502007531号
鄂公网安备42018502007531号

